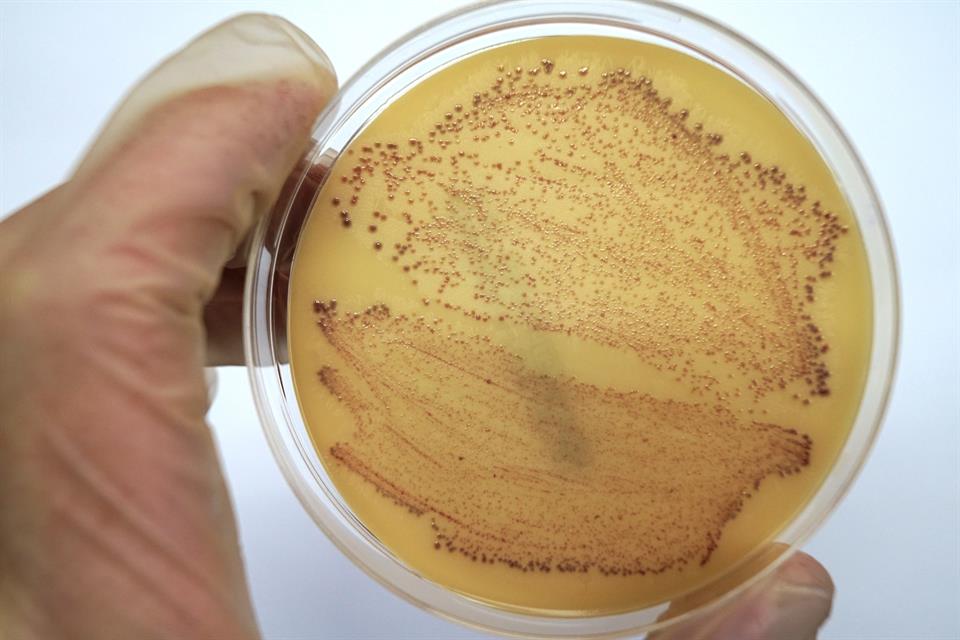

Vaksinasjon og medisinsk test
Når du skal ut i praksis eller ha klinisk undervisning, kan du risikere å bli utsett for smitte. Du kan også risikere å smitte andre. Du er sjølv ansvarleg for å få tatt dei tilrådde vaksinane og medisinske testane.
Her finn du informasjon om krav til vaksine og medisinsk testing, og kor du kan vaksinere eller teste deg.
Tuberkuloseundersøking
Du kan ha plikt til å undersøke deg for tuberkulose før du kan gå ut i praksis. Dette gjeld om du skal ut i praksis innan helse- og sosialfag, eller praksis i skule eller barnehage.

Når må du teste deg?
Du har plikt til å teste deg dersom du i løpet av dei tre siste åra har opphalde deg minst tre månadar i land med høg førekomst av tuberkulose.
Sjå Folkehelseinstituttet sin oversikt over land med høg førekomst av tuberkulose
Tuberkuloseundersøkinga
Quantiferon-testen skal takast 8–10 veker etter heimkomst/mulig eksponeringstid. Svar på røntgen thorax skal være negativ før du kan begynne i praksis.
Dersom du skal på utveksling til eit land med høg førekomst av tuberkulose, bør du bestille time for testing før du reiser. Snakk med kontaktpersonen din for utveksling om dette.
Også studentar ved Fakultet for lærarutdanning, kultur og idrett må vise tuberkulintest om dei har opphalde seg meir enn tre månader i land med høg førekomst av tuberkulose.
Tuberkoluseundersøking, kvar kan du ta kontakt?Om du får ei positiv tuberkuloseprøve
Om prøven er positiv, må du gjennomgå behandling. Ein positiv prøve kan, avhengig av smittestatus, gjere at du ikkje kan følge klinisk undervising saman med kullet ditt, og kan difor påverke studieprogresjonen din. Positiv prøve er ikkje til hinder for å følge den teoretiske delen av studia.
Du må melde frå til oss i praksisadministrasjonen for vidare oppfølging.
Meticillinresistente gule stafylokokker (MRSA)
Før du skal ha praksis eller klinisk undervisning på sjukehus eller i sjukeheim, kan du ha plikt til å teste deg for meticillinresistente gule stafylokokker (MRSA).
Når må du teste deg?
Du har plikt til å teste deg om du i løpet av dei siste tolv månadane har vore i eit land utanfor Norden der du har:
- arbeida som helsearbeidar, på barneheim eller i ein flyktningleir
- vore innlagt på helseinstitusjonar, fått omfattande undersøking eller behandling i ei helseteneste (ver merksam på at tatovering og piercing utført i utlandet er ein risiko)
Du har også plikt til å teste deg for MRSA om du har:
- budd i same husstand som MRSA-positive, eller hatt nær kontakt med MRSA-positive utan å nytte beskyttelsesutstyr
- tidlegare fått påvist MRSA, men ikkje seinare hatt tre negative kontrollprøver. Om MRSA er påvist i løpet av dei siste 12 månadane, må du teste deg for MRSA sjølv om seinare MRSA- prøvar har vore negative
- kliniske symptom på hud-eller sårinfeksjon, kroniske hudlidingar eller har lagt inn medisinsk utstyr gjennom hud eller slimhinner, og har oppholdt deg samanhengande i meir enn 6 veker i eit land utanfor Norden i løpet av dei siste 12 månadane
- fått tannbehandling i land utanfor Norden
- på andre måtar vore utsett for smitte i Norge, eller i utlandet i løpet av dei siste 12 månadane, eller om det er mistanke om smitte
Det kan vere strengare krav til dokumentasjon ved nokre praksisplassar der du må levere til dømes ein eigenerklæring.
Om du får ein positiv MRSA-prøve
Om prøven er positiv kan du ikkje delta i praksis eller klinisk undervising, og du må melde frå til oss i praksisadministrasjonen.
Du må gjennomgå behandling, og levere tre negative prøvar før du kan delta i klinisk undervising/praksis. Ein positiv prøve kan føre til at du ikkje får normal studieprogresjon ettersom du ikkje kan følge klinisk undervising saman med kullet ditt. Positiv prøve er ikkje til hinder for å følge den teoretiske delen av studia.
Vaksinasjon mot hepatitt B

Du bør vaksinere deg mot hepatitt B dersom du ikkje allereie er vaksinert. Dette gjeld særleg deg som er student ved:
- bioingeniørutdanning
- master jordmorfag
- master i klinisk sjukepleie med spesialitetane anestesisjukepleie, barnesjukepleie, intensivsjukepleie og operasjonssjukepleie
Om du ikkje er vaksinert kan du risikere å bli utsett for smitte, og du kan også risikere å smitte andre. Vaksineringa bør vere fullført før du har kontakt med pasientar.
Er du usikker på kva vaksiner du har teke og når, kan du sjekke vaksinetenesta på helsenorge.no.
Vaksine mot hepatitt B, kvar kan du ta kontakt?Vaksinasjon mot tuberkulose (BCG-vaksine)
Tuberkulose er ein bakteriesjukdom som smittar med luftsmitte. Det er lite tuberkulose i Noreg i dag, og det vert difor ikkje gitt rutinemessig BCG-vaksine til norske barn i barnevaksinasjonsprogrammet.
Folkehelseinstituttet si tilråding om BCG-vaksine i yrkessamanheng vil vanlegvis berre omfatte helsepersonell i spesialisthelsetenesta som over tid (ca. 3 månadar) skal arbeide med:
• vaksne pasientar med smittsam lungetuberkulose
• dyrking av mykobakterier i mikrobiologisk laboratorium
Ved særlige forhold og etter individuell vurdering kan BCG-vaksine også være aktuell for enkelte andre medarbeidar i helsetenesta, i fengsel eller i ankomstmottak, eller ved utanlandsreiser.
Oppfølging av barnevaksinasjonsprogrammet
Studentar og andre vert generelt anbefalt å følge opp vaksinene i barnevaksinasjonsprogrammet kvart 10. år. Ta kontakt med fastlegen din om dette.
Du kan sjekke vaksinasjonsstatusen din ved å logge deg inn på vaksinetenesta på helsenorge.no
Andre vaksiner
Når det gjeld vaksine mot influensa og vannkopper/varicella, må du særleg vurdere om anbefalinga i vaksineveilederen gjeld deg. Les meir på folkehelseinstituttet sine nettsidar.